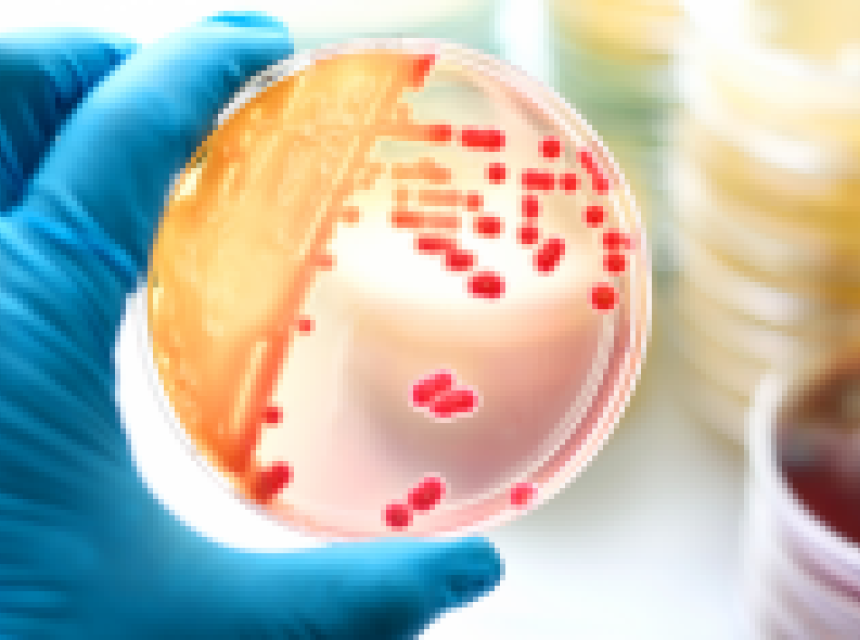

Bakterije se često nalaze na mjestima na kojima ih najmanje očekujemo pa ih tako možemo pronaći na stvarima koje koristimo za njegu lica ili na onima za nanošenje šminke. U nastavku pročitajte koje stvari iz vaše svakodnevice su najveće leglo bakterija. Mobitel Mobilni uređaji sastavni su dio svakodnevnog života, ali su pravo leglo mikroba. Prema jednoj studiji, više od 30 hiljada bakterija nalazi se na kvadratnom centimetru površine mobitela, a zagrijavanje samo pojačava negativan efekt. Naočale Naočale su izrazito opasne za osjetljivu kožu jer se nalaze u neposrednoj blizini nježne kože oko očiju. Osim toga, rizici se povećavaju zbog nakupljanja sebuma i mrtvih ćelija kože na njima. Četkice za šminku Ako vam se desilo da vam je četkica kojom nanosite šminku pala na pod pa čak i ako ste je odmah podignuli, bakterije su se već nastanile. Nipošto nemojte nastaviti šminkanje jer ćete tako na kožu nanijeti štetne čestice protiv kojih ćete se dugo boriti, a koje uzrokuju pojavu bubuljica i akni. Vodite računa s čime brišete lice Prema riječima brojnih dermatologa, peškir kojim brišete lice pravo je leglo bakterija i mikroba. Razlog leži u tome što se na vlažnom materijalu štetni mikroorganizmi razmnožavaju puno brže nego na suhom. Peškir kojim brišete lice trebali biste mijenjati svaki drugi dan i nikako ne biste smjeli koristiti isti peškir za lice i za tijelo. Jastučnica Znoj, ostatci kreme i mrve ćelije kože doprinose stvaranju bakterija. Jastučnicu na kojoj spavate trebali biste mijenjati svaka tri dana, a korištenje omekšivača strogo je zabranjeno ako želite zdravu kožu. Prekomjerna higijena Svoje lice trebali biste prati samo ujutro i navečer. U suprotnom, koža gubi svoju prirodnu zaštitnu barijeru i postaje preosjetljiva na mikrobe i bakterije.
Leglo bakterija! Na ovim stvarima iz naše svakodnevnice, živi više bakterija nego na podu kupatila
Svima nam je dobro poznato da su Sunčeva svjetlost, toksični sastojci u kozmetici i loše životne navike uzroci najvećih oštećenja kože. No, često zaboravljamo na bakterije koje se nalaze na stvarima koje svakodnevno koristimo.